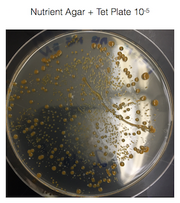

Uploads by Alison D. Bunnen
From OpenWetWare
Jump to navigationJump to search
This special page shows all uploaded files.
| Date | Name | Thumbnail | Size | Description |
|---|---|---|---|---|
| 02:47, 10 March 2015 | Abobservation7.png (file) |  |
147 KB | |
| 02:43, 10 March 2015 | Abobservations6.png (file) |  |
145 KB | |
| 02:35, 10 March 2015 | Abobservations5.png (file) |  |
220 KB | |
| 02:17, 10 March 2015 | Abobservations4.png (file) |  |
249 KB | |
| 01:59, 10 March 2015 | Abobservations3.png (file) |  |
195 KB | |
| 01:50, 10 March 2015 | Abobservations2.png (file) |  |
202 KB | |
| 01:48, 10 March 2015 | ABobservations2.png (file) |  |
203 KB | |
| 01:31, 10 March 2015 | ABobservation 1.png (file) |  |
139 KB | |
| 04:17, 28 February 2015 | Pcr product.jpg (file) |  |
38 KB | |
| 03:38, 28 February 2015 | AB invertebrates from transect.png (file) |  |
249 KB | |
| 02:43, 28 February 2015 | AB white mold.jpg (file) |  |
55 KB | |
| 02:12, 28 February 2015 | 5 sample plants AB.png (file) |  |
238 KB | |
| 20:11, 27 February 2015 | Bacteria characterization AB.png (file) |  |
151 KB | |
| 19:58, 27 February 2015 | Serial dilutions results .png (file) |  |
139 KB | |
| 23:58, 4 February 2015 | Bacteria characterists.png (file) |  |
176 KB | |
| 02:57, 4 February 2015 | Table 1 100 fold serial dilutions.png (file) |  |
95 KB | |
| 02:35, 4 February 2015 | Tet 10-9.png (file) |  |
162 KB | |
| 02:35, 4 February 2015 | Tet 10-7.png (file) |  |
167 KB | |
| 02:35, 4 February 2015 | Tet 10-5.png (file) | |
172 KB | |
| 02:34, 4 February 2015 | Tet 10-3.png (file) |  |
171 KB | |
| 02:06, 4 February 2015 | Nutrient 10-9.png (file) |  |
162 KB | |
| 02:05, 4 February 2015 | Nutrient 10-7.png (file) |  |
158 KB | |
| 02:04, 4 February 2015 | Nutrient 10-5 .png (file) |  |
167 KB | |
| 02:03, 4 February 2015 | Nutrient 10-3.png (file) |  |
159 KB | |
| 02:25, 30 January 2015 | Organism7.JPG (file) |  |
31 KB | |
| 02:22, 30 January 2015 | Organism6.JPG (file) |  |
25 KB | |
| 02:17, 30 January 2015 | Organism5.PNG (file) |  |
74 KB | |
| 02:12, 30 January 2015 | Organism4.jpg (file) |  |
22 KB | ~75μm |
| 02:05, 30 January 2015 | Organism3.jpg (file) |  |
24 KB | ~50μm |
| 01:57, 30 January 2015 | Organism2.jpg (file) |  |
24 KB | ~50μm depending on which one you looked at |
| 01:49, 30 January 2015 | Organism 1 AB.jpg (file) |  |
23 KB | Organism 1 is ~30 μm |
| 01:22, 30 January 2015 | Sideviewgroup3.JPG (file) |  |
45 KB | side view of my Hay Infusion Culture for Group 3 |
| 01:20, 30 January 2015 | Topviewgroup3.JPG (file) |  |
52 KB | Top view of Hay Infusion Culture for Group 3 |
| 23:29, 29 January 2015 | Niche Group 3 pic 2.png (file) |  |
134 KB | |
| 23:28, 29 January 2015 | Niche Group 3 pic 111.png (file) |  |
250 KB | Satellite view of Group 3's transect. |
| 23:17, 29 January 2015 | Aerial-view diagram111.png (file) |  |
81 KB | |
| 03:09, 27 January 2015 | Aerial-view diagram.png (file) |  |
298 KB | Aerial-view diagram of Group 3: Tall Bushes |
| 03:02, 27 January 2015 | Niche Group 3 pic 1.png (file) |  |
935 KB | Group 3 Transect |
| 02:55, 27 January 2015 | Screen Shot 2015-01-26 at 9.52.09 PM.png (file) |  |
180 KB | Transect: Tall Bushes |